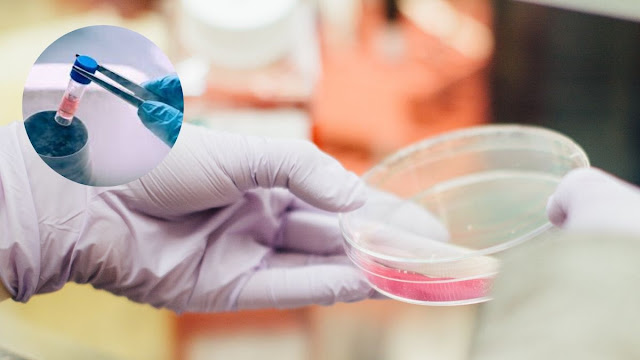

Embryo Freezing Cost in Jabalpur Affordable Option for Intended Parents
Planning to give birth to a healthy baby at a later age is one of the best decisions for a good number of women, who are worrying about their career. Embryo freezing is one of the best ways for them to make their dream come true. Embryo freezing cost in Jabalpur will be lower and counted as an ideal way for those, who cannot conceive naturally. As far as embryo freezing procedure is concerned, it is popularly known as embryo cryopreservation – a procedure of storing the unused embryos in liquid nitrogen at subzero temperature for use in later treatment cycle or for donation. It is one of the ideal ways for all those, who are planning to complete their families through this medically rich procedure. IVF Embryo Freezing Cost in Jabalpur or Embryo Freezing Cost in Jabalpur – Affordable and Ideal Solution For intended parents and even single male or female, embryo freezing Jabalpur is one of the best options to fulfill their desire and make their dream come true for a healthy baby through...